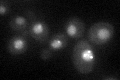
YHR154W
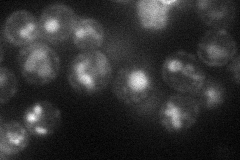
YHR154W
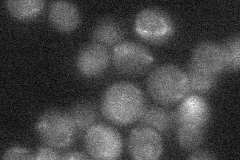
YHR154W

View description
Protein implicated in Mms22-dependent DNA repair during S phase, DNA damage induces phosphorylation by Mec1p at one or more SQ/TQ motifs; interacts with Mms22p and Slx4p; has four BRCT domains; has a role in regulation of Ty1 transposition
Localization:
Intensity:
Fold change:
Significance:
-
C’ GFP library in SD
nucleus, punctate28.51 -
N' NOP1pr-GFP in SD

cell periphery,ER,punctate57.431 -
N' TEF2pr-mCherry in SD
cell periphery,punctate,vacuole33.6218 -
N' NATIVEpr-GFP in SD
ambiguous21.4714 -
N' TEF2pr-VC and Cyto-VN in SD

#N/A0 -
C’ GFP library in SD+DTT

nucleus, punctate21.280.74Yes -
C’ GFP library in SD+H2O2

nucleus, punctate32.911.15No -
C’ GFP library in Starvation Media

nucleus, punctate19.80.69Yes -
C’ GFP library on the background of Pup2-DaMP

nucleus, punctate -
C’ GFP library on the background of CCT mutant

nucleus, punctate25.26570.885999No
